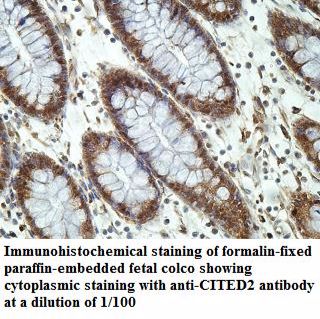
CITED2 Antibody

相关产品推荐更多 >
万千商家帮你免费找货
0 人在求购买到急需产品
- 详细信息
- 技术资料
- 供应商:
上海泽叶生物科技有限公司
- 库存:
100
- 靶点:
见说明书
- 级别:
高
- 目录编号:
ZY916940
- 克隆性:
多克隆
- 抗原来源:
多抗制备
- 保质期:
2年
- 抗体英文名:
CITED2
- 抗体名:
CITED2
- 标记物:
无标记物
- 宿主:
小鼠
- 适应物种:
Human Other species not tested.
- 免疫原:
详见说明书
- 亚型:
Ig亚型IgG
- 形态:
液体或冻干粉
- 应用范围:
见说明书
- 保存条件:
-20°C
- 浓度:
0.5mg/ml
- 规格:
50ul/100ul/200ul
| 规格: | 50ul | 产品价格: | ¥1050.0 |
|---|---|---|---|
| 规格: | 100ul | 产品价格: | ¥1500.0 |
| 规格: | 200ul | 产品价格: | ¥2300.0 |
CITED2 Antibody
| Catalog No | ZY916940 |
|---|---|
| Species Reactivity | Human Other species not tested. |
| Immunogen | A peptide corresponding to middle region of human CITED2 protein. |
| GeneBank No. | NM_006079 |
| Alternative Names | ASD8; MRG-1; MRG1; P35SRJ; VSD2 |
| Purification | Purified by antigen affinity column. |
| Isotype | IgG |
| Formulation | Lyophilized power with 1% BSA and 0.02% NaN3. Or dissolved in sterile H2O with 50% glycerol. |
| Concentration | 0.5mg/ml |
| Applications | |
|---|---|
| ELISA | 1:20,000-1:80,000 |
| Immunohistochemistry | 1:100-1:500 |
| For research use only. Optimal dilutions/concentrations should be determined by the final use. | |
| DATA | ||
|---|---|---|
|
|
||
| Observed Molecular Weight | ||
| PREPARATION AND STORAGE | |
|---|---|
| Reconstitution | If lyophilized, reconstitute in indicated volume of sterile H2O. For extended storage, we suggest the addition of an equal volume of glycerol to make a final glycerol concentration of 50%. |
| Storage | Shipped at ambient temperature or with ice bags if in liquid. Store immediately at-20°C upon receipt. Avoid repeating freeze-thaw cycles. |
风险提示:丁香通仅作为第三方平台,为商家信息发布提供平台空间。用户咨询产品时请注意保护个人信息及财产安全,合理判断,谨慎选购商品,商家和用户对交易行为负责。对于医疗器械类产品,请先查证核实企业经营资质和医疗器械产品注册证情况。
技术资料暂无技术资料 索取技术资料
CITED2 Antibody
¥1050 - 2300